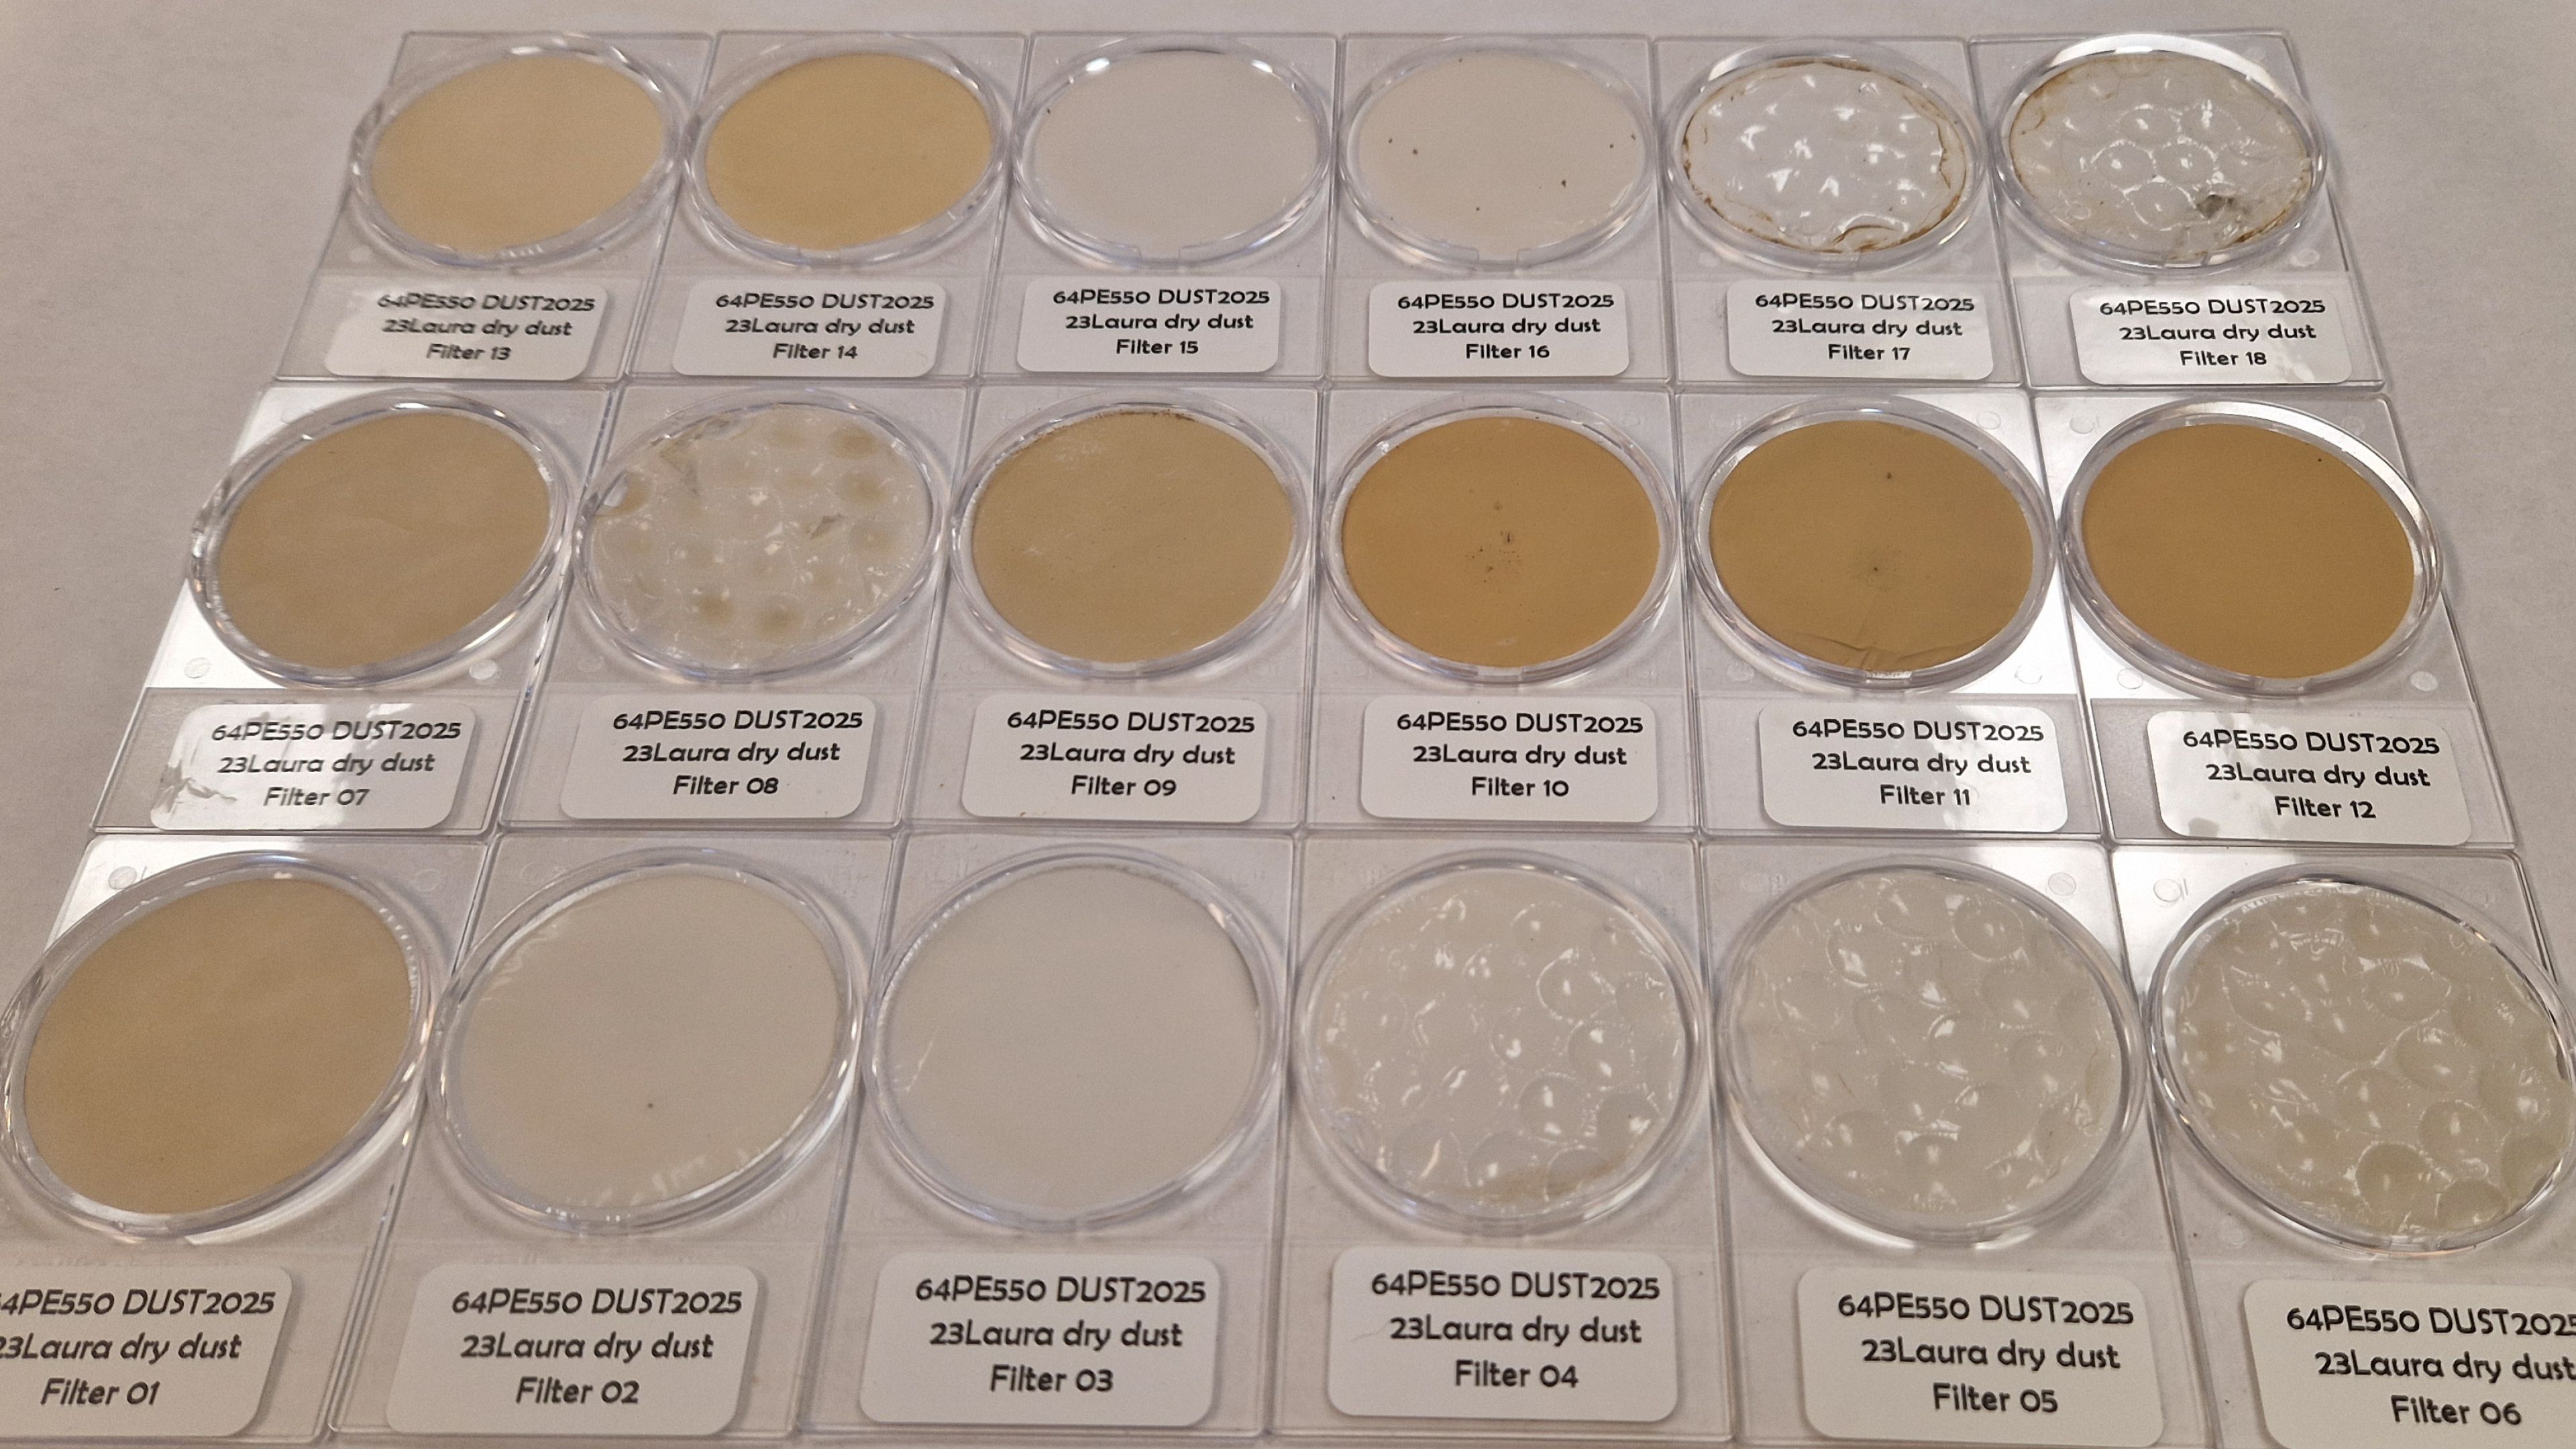
12 samples of dust in round glass trays

2025 in pictures
A selection of pictures taken by NIOZ employees gives an impression of their work in 2025.


Hailley Danielson-Owczynsky
Sampling and processing SIBES sampling in the Wadden Sea. Team work makes the dream work.


Henk de Haas
At the shipyard in Vigo, with RV Anna Weber-van Bosse under construction.

Zsuzsanna Toth
Looking for mussels during fieldwork of the Parasite-group. Paal 9 beach (Texel) in November.


Aimee Slangen
During ‘Wim Wolff Water Week’, students are introduced to marine research. An activity of the Delta Climate Centre. (Photos partly by Jordan Blok)


Anne Vorenkamp
Stormy weather on the Hors (Texel). And a feather of a bar-tailed godwit, captured and tagged on Griend.


Rob de Beer
Wind farm during a research cruise at sunset on the North Sea.


Dennis Mosk
Juvenile red mullet in fyke, North Sea crab, placing fyke poles, box-coring for SUBES on the RV Wim Wolff.


Hanna Stegeman
A bountiful catch: zooplankton sampling on the North Sea with a WP2 plankton net.


Dick van Oevelen
Sampling during the MONS project with Rijkswaterstaat. (Photos by Max van Hanegem)



Jan-Berend Stuut
Cape Verde, searching for dust buoys, deploying drifting traps, dusty harvest.

Max Burgoon
A reef fragment built by honeycomb worms (Sabellaria alveolata) in the Bay of Mont St Michel, France.


Bas de Wit
The student becomes the master. Intern Dennis showing senior scientist Anieke the finer elements of herring gonad staging.

Isla Botting
Misty sunrise on Griend. Four colour marked red knots are released on Griend.

Judith van Bleijswijk
The Molecular Ecology Laboratory is used by people from all four NIOZ scientific departments.


Jim van Belzen
Salt marses at the Zwin (Zeeland). Xiriton blocks are tested for suitability as a substrate for shell banks or salt marsh restoration. Jelly fish in Veerse Meer.




Kelly Kat
Sunset and dolphins during a sea trial of the RV Anna Weber-van Bosse. Last cruise on the RV Pelagia.



Rianne Lindhout
NOS reporter interviews Rosalinde van Ooijen about new species of Pacific barnacle in the Wadden Sea.

Lorendz Boom
Site team at Astilleros Armon shipyard in Vigo, during the construction of RV Anna Weber-van Bosse.


Lara Disselhoff
With PhD students on Research Vessel Zirfaea of Rijkswaterstaat, taking samples for the MONS project.




Remko de Haan
Assembly of the power controller for the Watlas project.
MaMa Course
Setting out the instruments on RV Adriaen Coenen during the Marine Masters Summer Course (MaMa).


Robert Twijnstra
A small spotted catshark caught in the fyke (and being released). Ulva sampling with students near the Cocksdorp (Texel).


Roeland Bom
Nets for catching shorebirds to determine migratory departure weights. Balgzand, early morning. Roeland Bom and Theunis Piersma discussing science while preparing dinner (Banc d’Arguin, Mauritania).


Victoria Mason
A muddy walk to take sediment cores in the Dutch Wadden Sea. Taking sunset dGPS measurements at Wierum.
